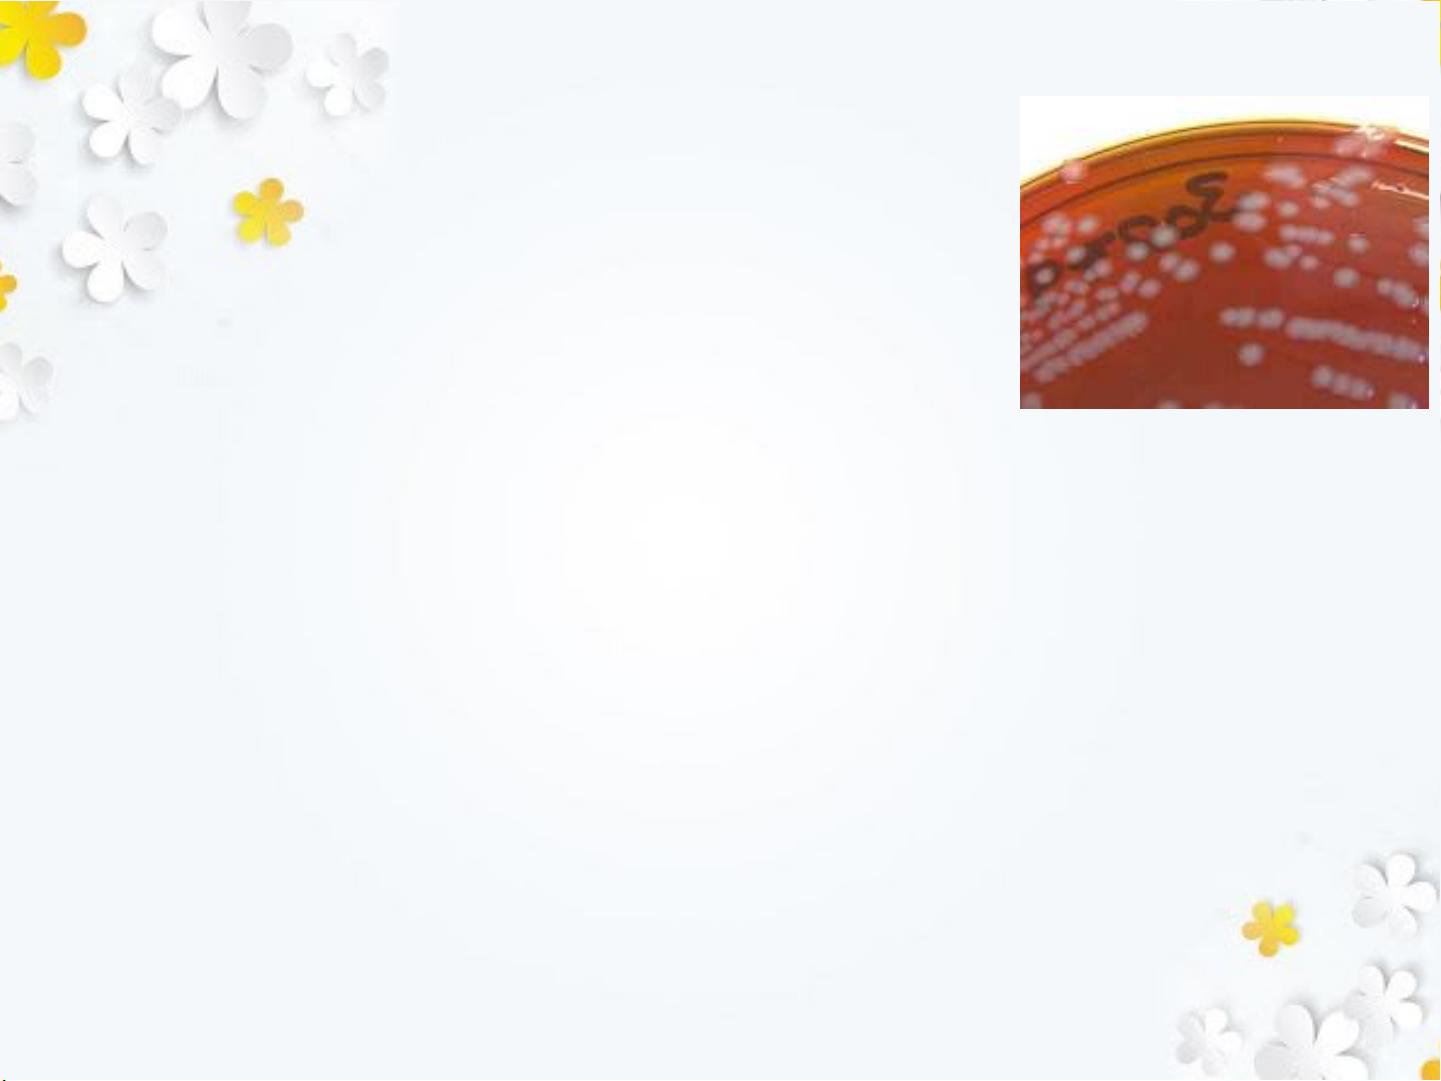

Bộ môn VI SINH – KHOA DƯỢC
ThS. DS PHẨM MINH THU
BỘ GIÁO DỤC VÀ ĐÀO TẠO
TRƯỜNG ĐẠI HỌC LẠC HỒNG

VI KHUẨN GÂY BỆNH LÂY LAN QUA
ĐƯỜNG SINH DỤC
1. Mô tả được đặc điểm hình dạng, cách xắp sếp
tính chất sinh hóa của nhóm vi khuẩn gây bệnh.
2. Biết được khả năng gây bệnh, triệu chứng và
một số biến chứng của bệnh do vi khuẩn gây ra
3. Nêu được phương pháp nhận định vi khuẩn.
4. Biết cách phòng ngừa và điều trị một số bệnh
do vi khuẩn gây ra qua đường sinh dục.

Vi khuẩn NEISSERIA GONORRHOEAE
N.gonorrhoeae do Neisser phân lập năm 1879
từ mủ ở đường sinh dục của bệnh nhân.
N.gonorrhoeae: gây bệnh lậu truyền trực tiếp
do quan hệ tình dục.

Đặc điểm sinh học:
Hình dạng
Song cầu khuẩn, úp đối mặt nhau giống như
2 hạt cà phê, Gram âm.
Vi khuẩn NEISSERIA GONORRHOEAE
Đặc điểm sinh học:
Nuôi cấy
−Hiếu khí kỵ khí tùy ý
−Trên môi trường: thạch máu, chocolate, Muller-
Hinton, cho khuẩnlạcto, lồi, óng ánh, nhày,
trong hay đục.
−Ủ ở 370C/3-10%CO2. Ko mọc ở 250C và 420C
thoạt tính sinh hóa, ko tan huyết, glucose (+),
oxidase (+).
Vi khuẩn NEISSERIA GONORRHOEAE

